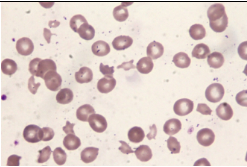
phpYpP6rw.png

2. 一位45歲男性,過去曾因為風濕性心臟病接受二尖瓣瓣膜置換術,其他無特殊病史。最近抽血發現血紅素 8.2 g/dL,MCV 108 fL,白血球 9,650/μL,血小板 209,000/μL,bilirubin全量(total) 5.1 mg/dL,直接型(direct) 0.80 mg/dL,GOT 234 IU/L,GPT 36 IU/L,LDH 4,300 IU/L,血液抹片如圖。此病人貧血最可能的原因為何? (A) Anemia related to liver disease (B) Iron deficiency anemia (C) Autoimmune hemolytic anemia (D) Mechanical hemolytic anemia (E) Thalassemia